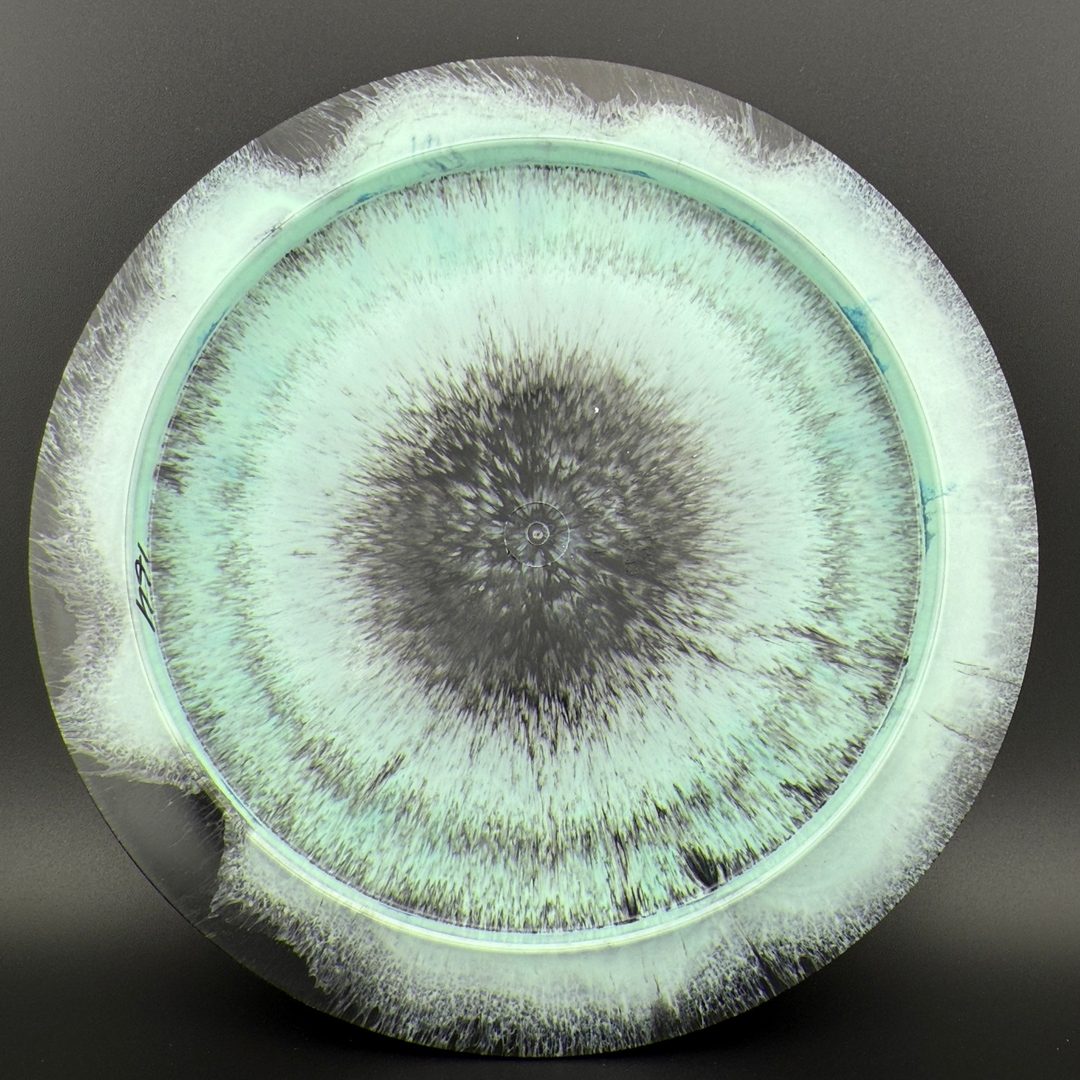
Elixir Idol - First Run - Face Stamp MINT Discs

MINT Discs
Elixir Idol - First Run - Face Stamp
Elixir Idol - First Run - Face Stamp
Couldn't load pickup availability
Product Description
Product Description
13/5/-1/2.5 *First run of the IDOL in the Elixir plastic! (#EX-ID01-25). Excellent grip to these just like Tour Series Prodigy, these will bomb. We are excited for these and no sharp edges!
The Mint Discs Idol is a high-speed driver with flight numbers 13/5/-1/2.5, built for players who want maximum distance with a dependable, late-fading finish. The slight turn in the early flight phase allows it to push down the fairway with impressive glide before its strong fade kicks in, making it great for controlled distance lines and windy-day confidence. It’s a power-friendly driver that can handle full rips without turning into a roller, yet still offers workable shot-shaping potential for skilled throwers.
Elixir Plastic from Mint Discs is a premium blend produced by Prodigy, sharing many characteristics with Prodigy’s high-end Tour Series plastics. It features a very slightly gummy yet durable feel that offers exceptional grip without sacrificing stability. The plastic often showcases rich, multi-tonal swirls and a subtle pearlescent sheen, giving each disc a one-of-a-kind look. Built for players who want top-tier performance with a touch of visual flair, Elixir pairs tour-level consistency with standout aesthetics.
Share